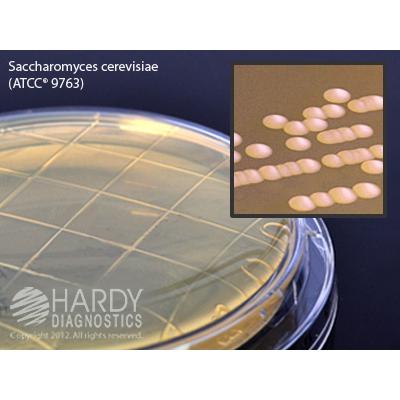

Malt Extract Agar with Lecithin and Tween, Hardy Diagnostics
$88
Image | SKU | Description | Quantity | Price | Add to Cart |
---|---|---|---|---|---|
![]() |
P93 | Malt Extract Agar with Lecithin and Tween | 10 Pack | $88 |
Description
Malt Extract Agar (MEA) is a general purpose agar for the isolation and cultivation of fungi (yeast and mold) from environmental surfaces.
Our Contact Plate Features
- New Tap tight™ Locking Lids
- Simply tap the contact plate lid to secure it into place.
- Molded Grid
- Each plate has a grid molded into the bottom of the plate to aid in the counting of microorganisms.
- Certificates of Analysis
- Available with each order!